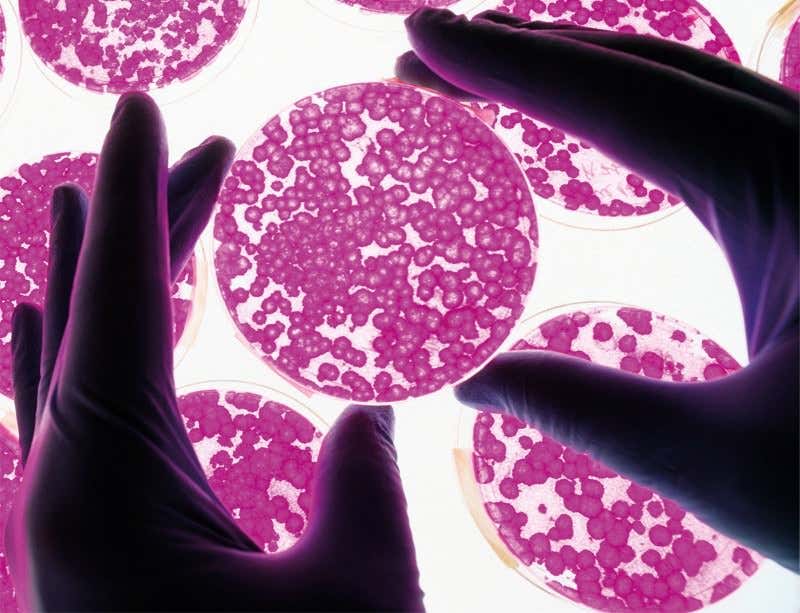
New Scientist. Science news and long reads from expert journalists, covering developments in science, technology, health and the environment on the website and the magazine.

The original multi-core processor (Image: Massimo Brega, The Lighthouse/Science Photo Library)
SOFTWARE used to keep bugs out of Microsoft Windows programs has begun shedding light on one of the big questions in modern science: how stem cells decide what type of tissue to become.
Not only do the results reveal that cellular decision-making is nowhere near as complicated as expected, they also raise hopes that the software could become a key tool in regenerative medicine.
“It is a sign of the convergence between carbon and silicon-based life,” says Chris Mason, a regenerative medicine specialist at University College London. “World-class stem cell scientists and a world-class computer company have found common ground. It is work at such interfaces that brings the big breakthroughs.”
Advertisement
“It’s a convergence between silicon and carbon-based life. Big breakthroughs happen at such interfaces”
Stem cells are the putty from which all tissues of the body are made. That means they have the potential to repair damaged tissue and even grow into new organs.
Embryonic stem cells hold particular promise as they can either renew themselves indefinitely or differentiate into any kind of cell in the body – a property known as pluripotency.
The process that sets a stem cell on the path to either self-renewal or differentiation was thought to be a highly complex web of genetic and environmental interactions. That web is known as the interactome.
Embryonic stem cells are currently being trialled as a way to restore vision and treat spinal injury. But these trials, and others in the pipeline, are hampered by the fact that no one really knows what determines the fate of any particular stem cell. Today’s techniques for making a stem cell differentiate into a certain tissues are hit-and-miss, says Mason.
What’s needed is a more deterministic, reliable method, says Sara-Jane Dunn, a computational biologist at Microsoft Research in Cambridge. One approach is to frame the problem in the language of computation. The genetic and environmental cues that determine the cell’s fate can be thought of as inputs, with the cell itself as the processor, Dunn says.
Stem cells’ capacity to renew themselves is the simplest of the two possible paths out of the pluripotent state. To find the program behind this, Dunn, along with stem cell scientists Graziano Martello at the University of Padua in Italy, and Austin Smith at the University of Cambridge, tried to isolate the genetic and environmental processes at work in mouse embryonic stem cells.
They used a technique pioneered at Smith’s lab that uses cultures of various inhibitory proteins to keep embryonic stem cells continually renewing themselves rather than differentiating into other cells. The team immersed the stem cells in four different types of these cultures and analysed which genes they expressed in which environment, and to what extent.
Next, to uncover the program that kept the cells in the unspecialised state, they turned to a mathematical technique called formal verification. Originally developed to detect and remove errors in software that keeps aircraft aloft and nuclear power plants safe, the technique is now widely used to eliminate bugs in commercial software, such as Microsoft’s Windows packages.
Formal verification examines the algorithms in a piece of software to check that the output will always be what the programmer intended. But it can also work back from the output to infer the nature of the algorithm creating it – just what Dunn’s team required.
The team rewrote the Microsoft formal verification program, then fed genetic and chemical data from the different stem cell cultures into it – with some surprising results. There appears to be no highly complicated interactome behind self-renewal. Instead, the stem cells’ program involved just 16 interactions between 12 proteins, called transcription factors, and three environmental inputs, in this case provided by chemicals in the lab. The relative simplicity of the process means biologists have a much greater chance of reliably influencing stem cell fate.
The researchers also found they could use the software – called the Reasoning Engine for Interaction Networks (RE:IN) – to predict with about 70 per cent accuracy how the cells would respond to genetic changes. For instance, they were able to predict whether the cell would remain pluripotent after knocking out one gene, or two (Science, doi.org/s5f).
The next step is to work out the underlying biological processes behind stem cell differentiation. Smith and Martello plan to encourage mouse embryonic stem cells to turn into neurons, using Microsoft’s formal analysis tools as a guide. They will also use it to study cell reprogramming, in which an adult cell is converted back into its pluripotent state.
“It’s remarkable. I have never seen anything like it,” says Mason. If this technique reveals the molecular program behind differentiation, it might enable us to do it in the lab more robustly, he says.
Simon Tomlinson from the Institute for Stem Cell Research in Edinburgh, UK, agrees that this is a big step forward. “It signals a future where many discoveries in this area are driven by predictive model building.”
The real test will be in repeating the results with human embryonic stem cells, says Robert Lanza at Advanced Cell Technology in Marlborough, Massachusetts, who is involved with the vision trial. “It’s usefulness will have to be determined over time.”
Clarification, 13 June 2014: We have made more explicit the relationship between the RE:IN software and the Microsoft software on which it was based.
Biology laid bare
Probing the secrets of stem cell programming (see main story) is just one of the challenges Microsoft’s formal verification software can take on. It will also be used to analyse gene signalling networks in cress, fruit flies and sea urchins.
Other powerful computers and techniques are taking aim at biological problems too: supercomputers are being wielded in a genomic fight against cancer. IBM’s Watson, the supercomputer that famously won the TV quiz Jeopardy! in 2011, is analysing gene sequences from the most aggressive types of brain tumours. Working with the New York Genome Center, IBM hopes Watson will show which therapies work best on tumours with different genomic profiles.
Another way to glean information from the genome is to check how it is folded – a perfect job for 3D analysis by a computer. This matters when diagnosing leukaemia, where overexpression of genes makes the cell’s genome change shape. Researchers at McGill University in Montreal, Canada, used this approach to diagnose leukaemia type with 93 per cent accuracy.
The aptness of computers decoding such puzzles will not be lost on historians: after inventing the digital computer, the British mathematician Alan Turing’s next obsession was morphogenesis – how organisms develop their shapes.
This article appeared in print under the headline “Anti-bug software foretells cell fate”
Topics:




